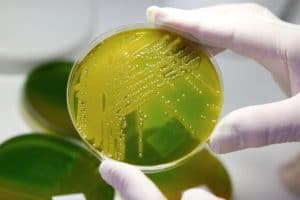

Il virus Zika potrebbe essere utilizzato per combattere il cancro al cervello
Secondo un team di scienziati statunitensi, il virus è in grado di eliminare le cellule staminali impazzite che resistono alla chemioterapia e alla radioterapia
Secondo i ricercatori statunitensi, il dannoso e potente virus Zika che ha causato danni cerebrali devastanti nei bambini – con oltre 210mila casi accertati nel 2016 solo in Brasile – potrebbe diventare parte di una sorprendente cura per il cancro al cervello.
Come riporta la Bbc, il terribile virus, isolato per la prima volta nel 1947, potrebbe diventare una risorsa per combattere uno dei tumori più temuti, proprio perché difficilissimo da sconfiggere.
Secondo quanto affermano gli scienziati, è proprio la dote “letale” del virus a essere utilizzata per eliminare le cellule staminali impazzite che resistono sia alla chemioterapia che alla radioterapia.
Il virus è infatti in grado di uccidere le cellule progenitrici dei neuroni e, secondo i risultati dei primi esperimenti condotti in laboratorio dai ricercatori dell’Università di Washington a Saint Louis e dell’Università della California a San Diego, la soluzione non sembrerebbe lontana.
I primi studi effettuati sui topi dimostrano l’efficacia dell’utilizzo del virus ma sono necessari ulteriori approfondimenti per capire se la pratica può essere utilizzata sugli essere umani.
“Abbiamo ipotizzato che la sua predilezione per le cellule progenitrici neurali potesse essere usata contro le staminali del glioblastoma”, ha spiegato il ricercatore Michael Diamond che fa parte del team di scienziati.
Come riportato dall’Ansa, dopo che il virus è stato sperimentato in provetta su cellule prelevate dai pazienti, ha dimostrato di colpire preferenzialmente le staminali del glioblastoma piuttosto che le cellule sane o le altre cellule dello stesso tumore.
Iniettato in topi malati, il virus ha rallentato la progressione del glioblastoma aumentando la sopravvivenza. L’esperimento è stato ripetuto con successo usando un secondo ceppo di Zika meno aggressivo, che può essere facilmente contenuto dal sistema immunitario in modo da non diffondere nell’organismo.
Il virus Zika è stato isolato per la prima volta in Uganda dalle scimmie della foresta Zika, vicino al lago Victoria. Il primo caso di infezione nell’uomo risale al 1968 in Nigeria e dal 1968 al 2007 si sono registrati casi di infezione umana solamente nell’Africa centrale e nel Sud Est asiatico. La prima epidemia si è verificata nel 2007 sull’isola di Yap (Micronesia), dove sono stati segnalati 185 casi sospetti.



























